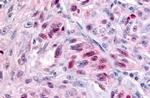
NR1D2 Antibody in Immunohistochemistry (Paraffin) (IHC (P))

Search
Invitrogen
NR1D2 Polyclonal Antibody
{{$productOrderCtrl.translations['antibody.pdp.commerceCard.promotion.promotions']}}
{{$productOrderCtrl.translations['antibody.pdp.commerceCard.promotion.viewpromo']}}
{{$productOrderCtrl.translations['antibody.pdp.commerceCard.promotion.promocode']}}: {{promo.promoCode}} {{promo.promoTitle}} {{promo.promoDescription}}. {{$productOrderCtrl.translations['antibody.pdp.commerceCard.promotion.learnmore']}}
产品信息
PA1-32853
种属反应
宿主/亚型
分类
类型
抗原
偶联物
形式
浓度
纯化类型
保存液
内含物
保存条件
运输条件
RRID
产品详细信息
PA1-32853 detects NR1D2 from human samples.
靶标信息
This gene encodes a member of the nuclear hormone receptor family, specifically the NR1 subfamily of receptors. The encoded protein functions as a transcriptional repressor and may play a role in circadian rhythms and carbohydrate and lipid metabolism. Alternatively spliced transcript variants have been described.
仅用于科研。不用于诊断过程。未经明确授权不得转售。
篇参考文献 (0)
生物信息学
蛋白别名: EAR-1R; HZF2; nuclear receptor Rev-ErbA beta variant 1; nuclear receptor Rev-ErbA beta variant 2; Nuclear receptor subfamily 1 group D member 2; Nuclear receptor subfamily 1 group D member 2-like protein; nuclear receptor subfamily 1, group D, member 2; Orphan nuclear hormone receptor BD73; Rev-erb alpha-related receptor; Rev-erb-beta; Rev-erba beta; rev-erba-alpha-related receptor; Rev-erbabeta; RVR; V-erbA-related protein 1-related
基因别名: BD73; EAR-1R; NR1D2; RVR
UniProt ID: (Human) Q14995
Entrez Gene ID: (Rabbit) 100349421, (Human) 9975, (Horse) 100060122, (Dog) 485643, (Bovine) 532076